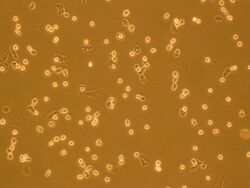

20.109(S12):Module 3
Module 3
Instructor: Agi Stachowiak
TA: Han-Hwa Hung
What makes a cell become one type and not another? How can we influence this process, and why would we even want to? When faced with conflicting information – in our own experiments, or in the broader scientific literature – how do we determine what is credible? These are just some of the questions you will explore in the third and final module, all in the context of tissue engineering. The goal of tissue engineering (also called regenerative medicine) is to repair tissues damaged by acute trauma or disease. Repair is stimulated by insertion of a porous scaffold at the wound or disease site; the scaffold may carry relevant mature or progenitor cells, and in some cases also soluble growth factors. In cartilage tissue, mature cells are called chondrocytes, and their progenitor cells are mesenchymal stem cells. Tissue regeneration shares many characteristics with natural tissue development, including the importance of appropriate cell differentiation and phenotype maintenance. You will perform a hypothesis-driven investigation of the effects of environmental manipulations on primary chondrocytes and/or mesenchymal stem cells. In particular, you will assess cell viability, genotype, and protein production, but the specific experimental question is up to you.
I gratefully acknowledge Professor Alan Grodzinsky and several members of his lab group (particularly Rachel Miller and Paul Kopesky), for their technical advice and stimulating discussions during the development of this module.

Module 3 Day 1: Start-up biomaterials engineering
Module 3 Day 2: Initiate cell culture
Note: 1 week between day 2 and day 3.
Module 3 Day 3: Testing cell viability
Module 3 Day 4: Preparing cells for analysis
Module 3 Day 5: Initiating transcript and protein assays
Module 3 Day 6: Transcript-level analysis
Module 3 Day 7: Protein-level and wrap-up analysis
Module 3 Day 8: Student presentations
